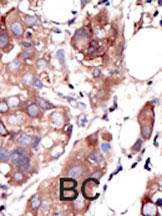

> Antigen, Antibodies, ELISA, Western Blot > Primary Antibody > Polyclonal Antibodies > MUSK Antibody (C-term)Brand |
Leading Biology | Catalog Number |
APR17486G |
Product Type |
Polyclonal Antibodies | Field of Research |
|
Product Overview |
We constantly strive to ensure we provide our customers with the best antibodies. As a result of this work we offer this antibody in purified format.
We are in the process of updating our datasheets. If you have any questions regarding this update, please feel free to contact our technical support team.
This product is a high quality MUSK antibody (C-term).
|
||
Molecular Weight |
97056 Da
|
||
Cellular Localization |
Antigen Cellular Localization:
Cell junction, synapse, postsynaptic cell membrane; Single-pass type I membrane protein. Note=Localizes to the postsynaptic cell membrane of the neuromuscular junction.
|
||
Host |
Rabbit
|
||
Species Reactivity |
Human
|
||
Immunogen |
829-859 aa
|
||
Target |
This MUSK antibody is generated from rabbits immunized with a KLH conjugated synthetic peptide between 829-859 amino acids from the C-terminal region of human MUSK.
|
||
Isotype |
Rabbit Ig
|
||
GeneID |
|||
UniProt ID |
|||
Function |
Receptor tyrosine kinase which plays a central role in the formation and the maintenance of the neuromuscular junction (NMJ), the synapse between the motor neuron and the skeletal muscle. Recruitment of AGRIN by LRP4 to the MUSK signaling complex induces phosphorylation and activation of MUSK, the kinase of the complex. The activation of MUSK in myotubes regulates the formation of NMJs through the regulation of different processes including the specific expression of genes in subsynaptic nuclei, the reorganization of the actin cytoskeleton and the clustering of the acetylcholine receptors (AChR) in the postsynaptic membrane. May regulate AChR phosphorylation and clustering through activation of ABL1 and Src family kinases which in turn regulate MUSK. DVL1 and PAK1 that form a ternary complex with MUSK are also important for MUSK-dependent regulation of AChR clustering. May positively regulate Rho family GTPases through FNTA. Mediates the phosphorylation of FNTA which promotes prenylation, recruitment to membranes and activation of RAC1 a regulator of the actin cytoskeleton and of gene expression. Other effectors of the MUSK signaling include DNAJA3 which functions downstream of MUSK. May also play a role within the central nervous system by mediating cholinergic responses, synaptic plasticity and memory formation (By similarity).
|
||
Summary |
Protein kinases are enzymes that transfer a phosphate group from a phosphate donor, generally the g phosphate of ATP, onto an acceptor amino acid in a substrate protein. By this basic mechanism, protein kinases mediate most of the signal transduction in eukaryotic cells, regulating cellular metabolism, transcription, cell cycle progression, cytoskeletal rearrangement and cell movement, apoptosis, and differentiation. With more than 500 gene products, the protein kinase family is one of the largest families of proteins in eukaryotes. The family has been classified in 8 major groups based on sequence comparison of their tyrosine (PTK) or serine/threonine (STK) kinase catalytic domains.The tyrosine kinase (TK) group is mainly involved in the regulation of cell-cell interactions such as differentiation, adhesion, motility and death. There are currently about 90 TK genes sequenced, 58 are of receptor protein TK (e.g. EGFR, EPH, FGFR, PDGFR, TRK, and VEGFR families), and 32 of cytosolic TK (e.g. ABL, FAK, JAK, and SRC families).
|
||
Form |
Purified monoclonal antibody supplied in PBS with 0.09% (W/V) sodium azide. This antibody is purified through a protein G column, followed by dialysis against PBS. |
||
Storage & Stability |
Store at +4°C short term. For long-term storage, aliquot and store at -20°C or below. Stable for 12 months at -20°C. Avoid repeated freeze-thaw cycles.
|
||
Applications |
FC, WB, IHC-P, E
|
||
Dilution |
FC~~1:10~50
WB~~1:1000
IHC-P~~1:50~100
|
||
Synonyms |
Muscle, skeletal receptor tyrosine-protein kinase, Muscle-specific tyrosine-protein kinase receptor, MuSK, Muscle-specific kinase receptor, MUSK
|
||
Images |

MUSK Antibody (C-term) (Cat. APR17486G) flow cytometric analysis of CEM cells (right histogram) compared to a negative control cell (left histogram).FITC-conjugated goat-anti-rabbit secondary antibodies were used for the analysis. 
Western blot analysis of anti-MUSK Pab (Cat. APR17486G) in placenta cell lysate. MUSK (Arrow) was detected using purified Pab. Secondary HRP-anti-rabbit was used for signal visualization with chemiluminescence.
Formalin-fixed and paraffin-embedded human cancer tissue reacted with the primary antibody, which was peroxidase-conjugated to the secondary antibody, followed by AEC staining. This data demonstrates the use of this antibody for immunohistochemistry; clinical relevance has not been evaluated. BC = breast carcinoma; HC = hepatocarcinoma. |
||
Specification |
|||
Quantity |
|
||
| Select | Brand | Catalog No. | Product Name | Pack Size | Type | Field of Research | Specification | Quantity | Price(USD) | |
| 1 | Leading Biology | APR03440G | ITGA11 Antibody (N-term) | 100 μl | Polyclonal Antibodies |
|
$495.00 | Add Ask | ||
| 2 | Leading Biology | APR04537G | CMIP Antibody (C-term) | 100 μl | Polyclonal Antibodies |
|
$495.00 | Add Ask | ||
| 3 | Leading Biology | APR12422G | Human H4 Histamine Receptor (extracellular) Antibody | 50 μl | Polyclonal Antibodies |
|
$695.00 | Add Ask | ||
| 4 | Leading Biology | APR03844G | UBE2W Antibody (C-term) | 100 μl | Polyclonal Antibodies |
|
$495.00 | Add Ask | ||
| 5 | Leading Biology | APR04349G | HECTD2 Antibody (N-term) | 100 μl | Polyclonal Antibodies |
|
$495.00 | Add Ask | ||
| 6 | Leading Biology | APR03502G | IGHG1 Antibody (Center) | 100 μl | Polyclonal Antibodies |
|
$495.00 | Add Ask |
 Leading Biology Inc.
2600 Hilltop DR, Building G, B Suite C138
Richmond, CA, 94806
Tel: 1-661-524(LBI)-0262
Email: info@leadingbiology.com
Leading Biology Inc.
2600 Hilltop DR, Building G, B Suite C138
Richmond, CA, 94806
Tel: 1-661-524(LBI)-0262
Email: info@leadingbiology.com
Complete this form and click send to ask us a question, request a quote or simply say hello.

You have 0 item in your cart

You have 0 item in your inquiry list
